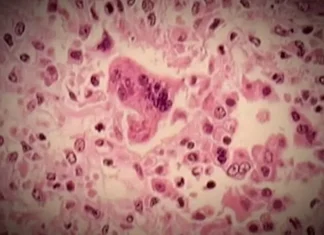
Alberta issues measles exposure alert for Stollery Children’s Hospital

Seven hospitalized in salmonella outbreak at Stoney Creek pub
Breadcrumb Trail LinksNewsOntarioToronto & GTAThose affected by the foodborne illness outbreak came down with symptoms between March 30 and April 5Published Apr 15,...
GLP-1 medicine improves liver health independent of weight loss
For years, the liver benefits of semaglutide have puzzled scientists. The drug was known to lower blood sugar and promote weight loss, but...
Sperm quality may change with the seasons, study finds
A new study suggests that human sperm quality follows a seasonal pattern, peaking in the summer and dipping in the winter.The research, published...
These simple acts will improve your health more than any fitness trend
This article contains affiliate links; if you click such a link and make a purchase, we may earn a commission.To receive Well Enough...
Dad, 34, slips into coma and loses all four limbs following routine dentist appointment
A man who went for a routine trip to the dentist ended up having all of his limbs amputated.34-year-old Davon Vanterpool visited the...
AllRock Bio begins patient dosing in Phase IIa ROCSTAR trial
AllRock Bio has dosed the first patients in the Phase IIa ROCSTAR clinical trial investigating ROC-101, an oral pan-rho-associated protein kinase (ROCK) inhibitor,...
3 small lifestyle changes can help you live longer, studies show
Five more minutes of sleep. Two more minutes of moderate exercise. And an extra half serving of vegetables. Doing these three things every...
Alberta issues measles exposure alert for Stollery Children’s Hospital
The province is warning the public about potential measles exposure at the Stollery Children's Hospital.In an advisory Tuesday, Alberta health officials said the...
Menopause marketing surges as doctors urge skepticism about hot flash products
Women suffering through the hot flashes, night sweats, mood changes and sleep problems that can come with menopause — all while looking in...